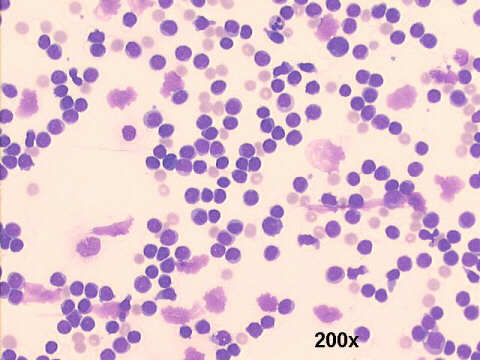
200x M-G-G staining

Pleural fluid, 19-year old female with ascites, fever and weight loss
Drs. Prolla and Diehl's
INTERESTING CASE OF THE MONTH May 2003 case A
Drs. Prolla and Diehl's INTERESTING CASE OF THE MONTH May 2003 case A
|
|

Case of the month answer
Click here for case B


 or case C
or case C